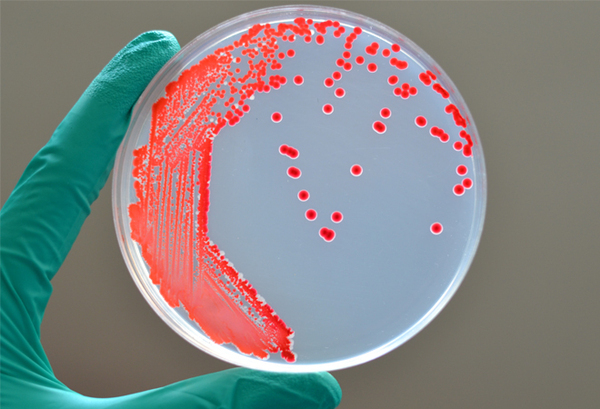
卵の異変に要注意！　殻をむいたら「え？」　白身がピンク色なワケ

卵の異変に要注意! 殻をむいたら「え?」 白身がピンク色なワケ

卵は、毎日の食卓に欠かせない食材です。
目玉焼きや卵焼き、オムレツなど、さまざまな料理で活躍してくれるため、冷蔵庫に常備している人も多いでしょう。
しかし、卵は傷みやすく、保存状態によっては見た目に異常が現れることもあります。
卵がピンク色になる原因は『セラチア菌』?
SNSなどで時折話題にのぼるのが、白身がピンク色になっている卵。
染めたわけでもなく、発色が鮮やかな卵を見て「かわいい」と感じる人もいるかもしれません。しかし、『思わぬ危険のサイン』である可能性があります。
卵の白身がピンクや赤みがかった色に変化している場合、『セラチア菌』という細菌が関係している可能性があります。
※写真はイメージ
『セラチア菌』は、水中や空気中など、さまざまな場所に分布。
湿度が高く、栄養分が豊富な環境を好んで増殖し、赤やピンクの色素を生成する特徴があります。
特に冷蔵庫内が汚れていたり、卵の殻に付着した汚れや水分が残っていたりすると、菌が増殖しやすくなる模様。
目黒区によると、ゆでた後の卵を汚染する場合があるそうです。

提供:目黒区保健所
この菌は加熱すれば死んでしまうので、ゆでた後に、殻の細かいひび割れや気孔から冷蔵庫内を汚染していたセラチア菌が侵入し保管中に繁殖したものと思われます。
目黒区ーより引用
『セラチア菌』で必ずしも重篤な食中毒になるわけではなく、健常者では無症状の場合も多いとされます。
とはいえ、免疫力の弱い人や乳幼児、高齢者では感染症の原因になることもあり、安全のためには「変色した卵は食べない」という判断が賢明です。
『セラチア菌』を防ぐには?家庭でできる対策

※写真はイメージ
『セラチア菌』の繁殖を防ぐために、日常生活で取り入れやすい対策をいくつかご紹介します。
卵は洗わずに冷蔵保存を
卵の殻には自然の保護膜『クチクラ層』があり、洗うと逆に雑菌が入りやすくなってしまいます。
汚れが気になる場合は、調理直前に拭き取る程度にしましょう。
卵の保管は10℃以下が基本
『セラチア菌』は、冷蔵保存することで増殖スピードをある程度は抑えることができます。
購入後は速やかに冷蔵庫へ入れ、ドアポケットではなく、温度変化の少ない奥側に置くのがおすすめです。
冷蔵庫内の掃除をこまめに
ドアポケットや卵ケースの底は、知らず知らずのうちに水分や汚れが溜まりやすくなります。
アルコールスプレーや台所用除菌シートなどを使って、定期的に掃除しましょう。

※写真はイメージ
卵の異変に気付いたら「もったいない」より「安全第一」
変色した卵は、一見すると珍しくて興味を引くかもしれませんが、惑わされてはいけません。
細菌による異常のサインである可能性がある以上、無理に食べずに処分する判断が必要です。
いつもの卵でも、よく観察すればちょっとした異変に気付けるもの。
『セラチア菌』に限らず、殻にカビのような斑点がないか、白身や黄身に濁りや変色がないかをチェックしてから調理する習慣を身につけて、安全でおいしい食卓を守りましょう。

札幌を中心にフードコーディネーター、料理研究家、離乳食研究家、料理講師、栄養士、ライターとして活動。幼い頃から料理上手な母親の手伝いをする中で、食に興味を持ち始め、短期大学時に栄養士資格を取得。卒業後はタレント活動の道を選び、レポーターとして北海道内の食に多く触れる。
ある日、突然「あれ、私の料理あんまりおいしくないかも?」と感じるようになり、本格的に食の勉強を開始。フードコーディネーターとしてのスキルを磨き、現在は企業のレシピ開発、撮影のスタイリング、テレビ出演、雑誌掲載などを行うフードコーディネーターとして活躍中。
⇒Instaragram
[文・構成/grape編集部]




